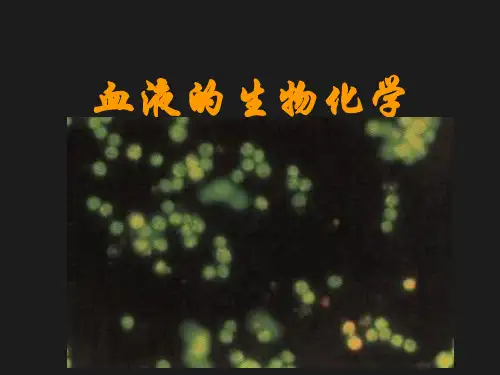

第十六章-血液的生物化学PPT课件
- 格式:ppt
- 大小:1.58 MB
- 文档页数:26

第十六章血液的生物化学Biochemistry of blood一、授课章节及主要内容:第十六章血液的生物化学二、授课对象:临床医学、预防、法医(五年制)、临床医学(七年制)本科五年制三、授课学时:本章共2节课时(每个课时为45分钟)。
讲授安排如下:第1个学时的讲课内容包括:概述、第一节以及第三节至红细胞的糖代谢(358页)。
第2个学时的内容包括:红细胞的脂代谢和血红蛋白的合成与调节,以及对全章的小结四、教学目的与要求:掌握以下知识点:1.血浆蛋白的功能;2.红细胞的糖代谢;3.血红素生物合成的组织和亚细胞定位、合成原料、限速反应、关键酶及血红素合成的调节。
熟悉以下内容:1.血液的概况;2.血浆蛋白的性质。
五、重点与难点重点:血浆蛋白的功能。
红细胞的代谢及血红素的生物合成。
难点:2, 3-BPG的功能及血红素生物合成的各步反应以及高铁血红素促进血红蛋白合成的机制。
六、教学方法及安排;教学方法:配合多媒体教学,课堂中穿插复习、提问,突出重点,讲清楚难点,进行必要的板书,读写重要词汇的英文单词。
以提问和回顾的方式进行小结,布置课后习题。
部分课程安排自学。
白细胞的代谢安排学生自学。
并布置课后习题。
七、主要外文专业词汇血液(blood)血浆(plasma)血清(serum)多态性(polymorphism)急性时相蛋白质(acute phase protein APP)红细胞(erythuocyte)2,3-二磷酸甘油酸(2,3-biphosphoglycerate,2,3-B(D)PG)血红素(heme)珠蛋白(globin)肌红蛋白(myoglobin)过氧化氢酶(catalase)过氧化物酶(peroxidase)δ-氨基-γ-酮戊酸(δ-aminolevulinic acid,ALA)原卟啉(protoporphyrin )尿卟啉原(uroporphyrinogen )粪卟啉原(coproporphyrinogen )促红细胞生成素(erythropoiefin,EPO)卟啉症(porphyria)八、思考题1.简述血液的组成。



